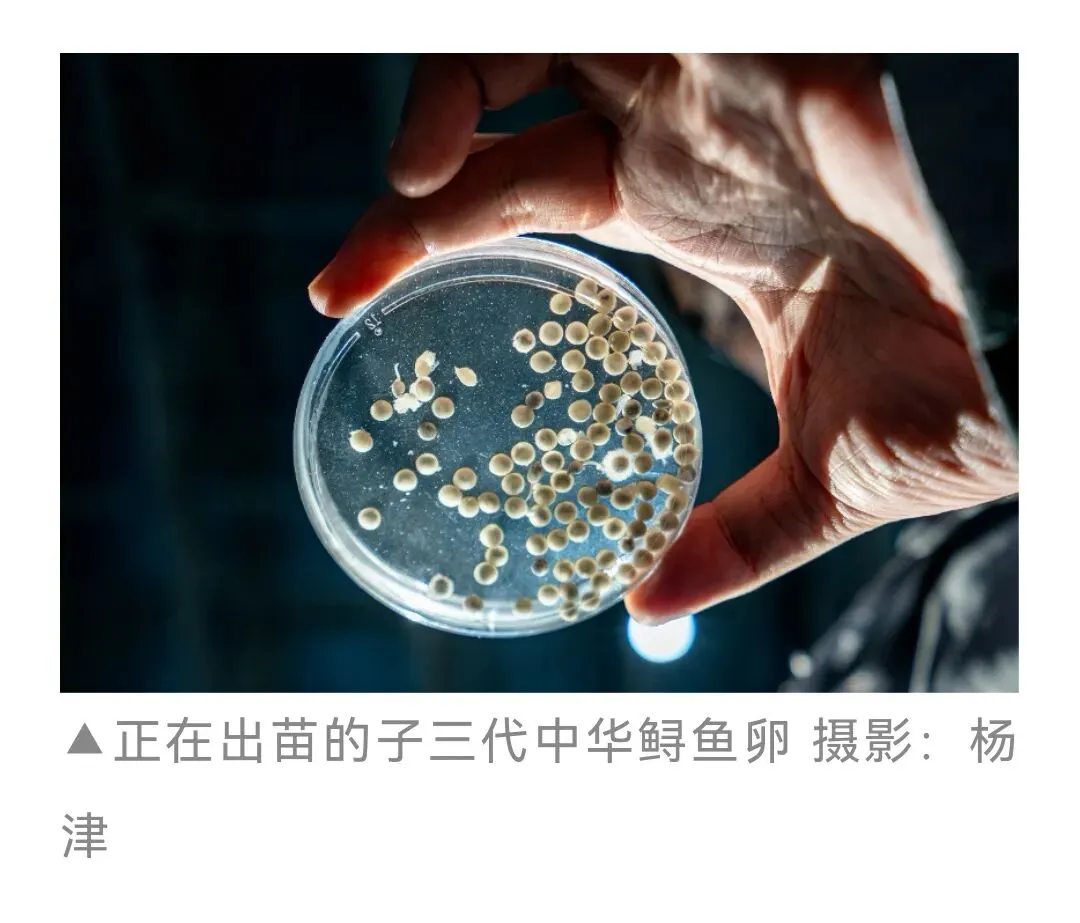

General Overview

中国三峡集团在长江干流建设运营的葛洲坝、三峡、向家坝、溪洛渡、白鹤滩、乌东德等六座巨型梯级水电站,通过联合调度、协同运行,共同组成了世界最大清洁能源走廊。
Hello everyone! What you are seeing now is the six giant cascading hydropower stations ------Gezhouba, Three Gorges, Xiangjiaba, Xiluodu, Baihetan, and Wudongde ------- constructed and operated by China Three Gorges Corporation(CTG) on the mainstream of the Yangtze River. Through joint scheduling and coordinated operation, they form the world’s largest clean energy corridor.


从葛洲坝到乌东德距离约1800公里,其水头总落差约900米。六座电站总装机7169.5万千瓦,相当于“三个三峡大坝”总装机容量,年均发电量约3000亿千瓦时,可满足3亿中国人一年的用电需求,可以有效缓解华中、华东地区及川、滇、粤等省份的用电紧张,为电网安全稳定运行和“西电东送”提供有力支撑,助力我国实现“碳达峰、碳中和”目标。
The distance from Gezhouba to Wudongde is approximately 1,800 kilometers, with a total water head drop of about 900 meters. The six power stations have a total installed capacity of 71695 MW, equivalent to the combined installed capacity of "three Three Gorges Projects." Their average annual power generation is approximately 300 billion kilowatt-hours, enough to meet the annual electricity demand of 360 million Chinese people. This helps alleviate electricity shortages in Central China, East China, and provinces such as Sichuan, Yunnan, and Guangdong, providing strong support for the safe and stable operation of the power grid and the "West-to-East Power Transmission" project. It also contributes to China’s goals of achieving "carbon peak and carbon neutrality."


从万里长江第一坝葛洲坝工程开工建设,到兴建世界最大水利枢纽工程三峡工程,再到白鹤滩电站安装的世界单机容量最大的一百万千瓦水能发电机组投产发电,这条清洁能源走廊的建设跨越半个世纪。中国水电建设坚持自力更生、创新发展,攻克了一系列世界级技术难题,实现了中国水电从“跟跑”、“并跑”再到“领跑”世界的历史性跨越。
From the construction of Gezhouba, the first dam on the Yangtze River, to the building of the Three Gorges Project, the world’s largest hydropower station, and to the commissioning of the world’s largest single-unit capacity 1000 MW hydropower generators at Baihetan, the construction of this clean energy corridor has spanned over half a century. China’s hydropower development has adhered to the principles of self-reliance and innovation, overcoming a series of world-class technical challenges and achieving a historic leap from "catching up" and "keeping pace" to "leading" the world in hydropower technology.


党的十八大以来,乌东德、白鹤滩两座世界级水电站相继开工并建成投产,世界上最大清洁能源走廊如期建成,全面发挥防洪、发电、补水、水生态保护等效益。同时,中国三峡集团充分发挥长江大保护骨干主力作用,助力长江生态环境发生转折性变化,为促进经济社会发展全面绿色转型、建设人与自然和谐共生的美丽中国贡献更大力量。
Since the 18th National Congress of the Communist Party of China, two world-class hydropower stations, Wudongde and Baihetan, have been successively constructed and put into operation. The world’s largest clean energy corridor has been completed as scheduled, fully realizing benefits in flood control, power generation, water replenishment, and aquatic ecological protection. At the same time, CTG has played a pivotal role in the Yangtze River conservation efforts, contributing to transformative improvements in the river’s ecological environment. It continues to make significant contributions to promoting a comprehensive green transformation in economic and social development and building a beautiful China where humanity and nature coexist harmoniously.







2025年世界最大清洁能源走廊安全精益运行,大国重器综合效益充分发挥,为保障长江防洪安全、供水安全、航运安全、能源安全和生态安全筑牢坚固屏障。
In 2025, the world's largest clean energy corridor operated with safety and precision, fully realizing the comprehensive benefits of these vital national infrastructures. It established a solid barrier for the safety of the Yangtze River in terms of flood control, water supply, navigation, energy, and ecology.

世界最大清洁能源走廊模型/全球能源互联网大会展览
这一年,面对华西地区1961年以来的“最强秋雨”,在蓄水期实施防洪调度,为长江水旱灾害防御作出了突出贡献。
This year, in the face of the "strongest autumn rains" in western China since 1961, the corridor implemented flood control scheduling during the impoundment period, making an outstanding contribution to flood and drought disaster prevention for the Yangtze River.
这一年,世界最大清洁能源走廊充分发挥战略性淡水资源库作用,累计向长江中下游补水252亿立方米。
This year, the world's largest clean energy corridor fully leveraged its role as a strategic freshwater reservoir, supplementing a total of 25.2 billion cubic meters of water to the middle and lower reaches of the Yangtze River.
这一年,三峡船闸和三峡升船机稳定高效运行。其中,三峡船闸货运量突破1.69亿吨,三峡升船机年客运量63万多人次。向家坝水电站全年通过货运量突破1000万吨,创历史新高,助力长江黄金水道效益进一步向金沙江下游拓展。
This year, the Three Gorges ship locks and the Three Gorges ship lift operated stably and efficiently. The cargo throughput of the Three Gorges ship locks exceeded 169 million tons, and the annual passenger volume of the Three Gorges ship lift surpassed 630,000 trips. The Xiangjiaba Hydropower Station's annual cargo throughput exceeded 10 million tons, setting a new record and helping to further extend the benefits of the Yangtze River's "golden waterway" into the lower reaches of the Jinsha River.
这一年,三峡集团圆满完成纪念中国人民抗日战争暨世界反法西斯战争胜利80周年阅兵式、党的二十届四中全会等多轮次国家重大活动电力保供任务。迎峰度夏期间,能源保供“压舱石”“顶梁柱”作用得到充分彰显。
This year, CTG strengthened its core capability in the joint operation of cascade reservoirs. It successfully completed multiple tasks of ensuring power supply for major national events, including the military parade for the 80th anniversary of the victory in the Chinese People's War of Resistance against Japanese Aggression and the World Anti-Fascist War, and the Fourth Plenary Session of the 20th Communist Party of China Central Committee. During the peak summer period, its role as the "ballast stone" and "pillar" of energy security was fully demonstrated.
这一年,开展3类13次生态调度及2次三峡水库库尾减淤调度。在三峡水库开展促进产漂流性卵鱼类自然繁殖生态调度试验期间,有效促进长江生态保护与生物多样性恢复。
This year, a total of 13 ecological operations across 3 categories and 2 sediment reduction operations in the tail area of the Three Gorges Reservoir were carried out. Notably, during the ecological operation tests in the Three Gorges Reservoir designed to promote the natural reproduction of fish species that spawn drifting eggs, effectively promoting ecological protection and biodiversity restoration in the Yangtze Rive.